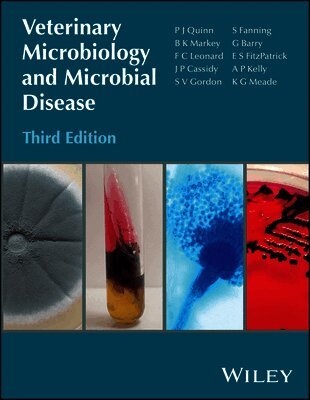

P. J. Quinn – författare
Visar alla böcker från författaren P. J. Quinn. Handla med fri frakt och snabb leverans.
6 produkter
6 produkter
1 240 kr
Skickas
Microbiology is one of the core subjects for veterinary students, and since its first publication in 2002, Veterinary Microbiology and Microbial Disease has become an essential text for students of veterinary medicine. Fully revised and expanded, this new edition updates the subject for pre-clinical and clinical veterinary students in a comprehensive manner. Individual sections deal with bacteriology, mycology and virology. Written by an academic team with many years of teaching experience, the book provides concise descriptions of groups of microorganisms and the diseases which they cause. Microbial pathogens are discussed in separate chapters which provide information on the more important features of each microorganism and its role in the pathogenesis of diseases of animals. The international and public health significance of these pathogens are reviewed comprehensively. The final section is concerned with the host and is organized according to the body system affected. Tables, boxes and flow diagrams provide information in an easily assimilated format. This edition contains new chapters on molecular diagnostics and on infectious conditions of the skin, cardiovascular system, urinary tract and musculoskeletal system. Many new colour diagrams are incorporated into this edition and each chapter has been updated.Key features of this edition: Twelve new chapters includedNumerous new illustrationsEach chapter has been updatedCompletely re-designed in full colourFulfils the needs of veterinary students and academics in veterinary microbiologyCompanion website with figures from the book as Powerpoints for viewing or downloading by chapter: www.wiley.com/go/quinn/veterinarymicrobiologyVeterinary Microbiology and Microbial Disease remains indispensable for all those studying and teaching this essential component of the veterinary curriculum.
168 kr
Skickas inom 5-8 vardagar
479 kr
Skickas
Updated to reflect the latest developments in the field, Concise Review of Veterinary Microbiology, 2nd Edition, presents essential information on veterinary microbiology for students and those requiring a refresher on key topics relating to microbial diseases in animals. Morphological, cultural and other descriptive features of pathogenic microorganisms are described, together with their habitats and aetiological roles in disease production in animals and, where appropriate, in the human population.Key features:• There are five sections covering bacteriology, mycology, virology, biosecurity and other aspects of infectious diseases• Provides concise, yet comprehensive information on pathogenic microorganisms of importance in veterinary medicine, the diseases which they cause, their diagnosis and control• The 79 short chapters in this book include 13 new chapters on antibacterial resistance, structure and function of the immune system, antifungal chemotherapy, antiviral chemotherapy, principles of biosecurity and a number of topics related to the control and prevention of infectious diseases• This latest edition uses updated nomenclature and includes detailed diagrams now in full colour, and comprehensive tables
816 kr
Skickas inom 5-8 vardagar
Veterinary Embryology, 2nd Edition, has been updated to reflect the many changes that have developed in the field; the text has been fully revised and expanded and is now in full colour and many pedagogical features and a companion website have been developed. A new edition of this highly successful student textbook, updated to reflect the latest developments in the field of embryology, with the inclusion of four new chaptersWritten by a team of authors with extensive experience of teaching this subjectShort concise chapters on key topics describe complex concepts in a user-friendly wayAdditional tables, flow diagrams and numerous hand-drawn illustrations support the concepts presented in the text
1 207 kr
Skickas
The definitive resource for understanding infectious disease in veterinary medicine The revised third edition of Veterinary Microbiology and Microbial Disease equips veterinary professionals with essential knowledge of bacteriology, mycology and virology. Serving as both an authoritative reference and practical clinical guide to infectious disease, the authors provide up-to-date information relevant to animal and public health, along with the latest diagnostic tools and the information required to treat and control them. This new edition incorporates substantial advances in molecular biology and genome sequencing that have transformed veterinary microbiology. New material also addresses contemporary challenges in infectious disease management, such as drug-resistant microorganisms, zoonotic pathogens, and other emerging threats. Readers will find: Expanded coverage of molecular diagnostic methods and genome sequencing for pathogen identification and characterizationComprehensive analysis of antibacterial resistance mechanisms, multiple drug resistance patterns, and their implications for zoonotic and nosocomial pathogensUpdated taxonomy of important pathogens in line with the recommendations of international committeesColour photographs illustrating important grossly- and microscopically-visible responses to infectious agentsA fully revised section on the interactions of microbial pathogens with animal body systems to facilitate a systematic approach to investigating the role of infectious agents in disease production and differential diagnosisAccess to a companion website providing all figures from the text as downloadable slides for educational useVeterinary Microbiology and Microbial Disease provides undergraduate and postgraduate veterinary students, practicing veterinary surgeons, researchers, and graduates specializing in diagnostic microbiology or regulatory activities with up-to-date information on bacterial, fungal, and viral pathogens.
168 kr
Skickas inom 5-8 vardagar